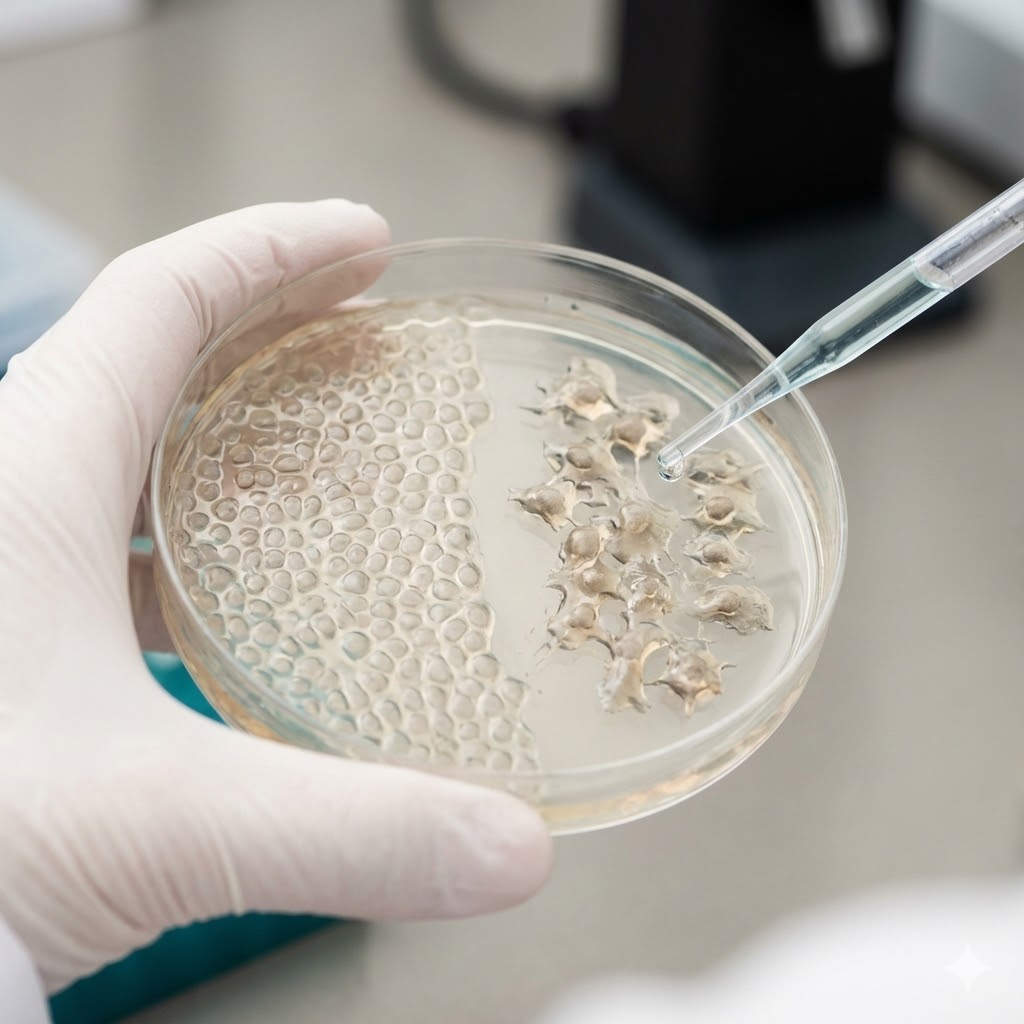
Valter Longo protokol symboliseret ved petriskål med hvid masse. en pipette tilfører væske.

Valter Longo Protokol
Resumé om Valter Longo protokol
Protokollens formål:
- At beskytte kroppens raske celler mod bivirkninger fra kemoterapi og samtidig gøre kræftceller mere sårbare over for behandling ved at manipulere kroppens næringsindtag. Målet er at opnå effekten af faste uden at skulle undvære mad fuldstændigt.
Indhold:
- Tilgangen er en periodisk 5-dages diæt (Fasting Mimicking Diet), der består af nøje afstemte, plantebaserede fødevarer (supper, nødder, te), som snyder kroppen til at tro, at den faster.
Den centrale idé:
- Filosofien er videnskabeligt funderet “metabolisk stress”. Ved midlertidigt at fjerne sukker og proteiner tvinges kroppen i en beskyttelsestilstand. Raske celler går i dvale og beskyttes (som et skjold), mens kræftceller, der ikke kan stoppe deres vækst, udsultes og bliver stressede, hvilket gør dem lette at dræbe med standardbehandling.
Hvem er Valter Longo

Valter Longo er en anerkendt italiensk-amerikansk biogerontolog og cellebiolog. Han er professor ved University of Southern California (USC) og direktør for Longevity Institute. [1]
I modsætning til mange alternative behandlere er Longo en etableret forsker, der har dedikeret årtier til at forstå aldring og cellernes reaktion på sult. Han er opfinder af FMD (Fasting Mimicking Diet) og forfatter til bogen “The Longevity Diet”. Han er kendt for at have opdaget de specifikke gener og signalveje (som IGF-1), der styrer cellernes ældning og resistens over for stress.
Hans arbejde bygger ikke på anekdoter, men på omfattende kliniske forsøg og grundforskning, der har banet vejen for en ny forståelse af kostens rolle i kræftbehandling.
Kræftens akilleshæl: Metabolisk stivhed

For at forstå, hvorfor en diæt kan forstærke kemoterapi, må man forstå forskellen på raske celler og kræftceller. Longo udnytter fænomenet “Differential Stress Resistance”.
Beskyttelse af det raske
Når kroppen mangler næring, har raske celler en evolutionær mekanisme: De lukker ned for vækst og bruger al energi på reparation og beskyttelse. De bygger så at sige et skjold omkring sig. Det betyder, at når kemoterapien rammer, preller den af på de raske celler, fordi de er inaktive.
Stress af det syge
Kræftceller har mistet denne evne. På grund af mutationer (onkogener) er de låst fast i en tilstand af konstant vækst med “speederen i bund”. De kan ikke gå i dvale, selvom der mangler mad.
Når man fjerner sukker og vækstfaktorer (via diæten), opstår der en krise i kræftcellen. Den forsøger desperat at vokse uden brændstof. Rammes den med kemoterapi i denne tilstand, kollapser den langt hurtigere end normalt. Dette kaldes “Differential Stress Sensitization”. [2, 3]
Sænkning af IGF-1
Forskning viser, at høje niveauer af vækstfaktoren IGF-1 fremmer kræft. Longos protokol sænker effektivt IGF-1 niveauerne dramatisk i løbet af de fem dage, hvilket fjerner en af tumorens vigtigste vækstsignaler.
Protokollens opskrift og dosering

Strategien er præcis og kræver overholdelse af makronæringsstofferne for at virke. Man kan enten købe en færdig pakke (ProLon) eller forsøge at sammensætte det selv (DIY), selvom Longo anbefaler det første for sikkerhed.
Strukturen (cyklussen)
Dette er ikke en permanent diæt, men en kur man tager i cyklusser.
- Varighed: 5 dage i træk.
- Frekvens: Typisk én gang om måneden i forbindelse med kemoterapi (startende 3 dage før kemoen og sluttende 24 timer efter, afhængigt af kemo-typen).
Dag 1 (overgang)
Kroppen skal vænnes til lavt kalorieindtag.
- Kalorier: Ca. 1100 kcal.
- Fordeling: 10% protein, 56% fedt, 34% kulhydrat.
- Indhold: Måltiderne består af komplekse kulhydrater (grøntsager), sunde fedtstoffer (nødder, olivenolie) og vegetabilsk protein. Ingen kød, ingen mælk, ingen sukker.
Dag 2-5 (ketose og faste)
Her går kroppen i den dybe beskyttelsestilstand.
- Kalorier: Ca. 700-800 kcal dagligt.
- Fordeling: 9% protein, 44% fedt, 47% kulhydrat.
- Indhold: Fokus på grøntsagssupper, urtete, nøddebarer og eventuelt kosttilskud (multivitamin/ omega-3) for at undgå mangler.
- Mål: At holde blodsukkeret lavt og ketonstofferne høje.
Genopbygning (dag 6)
Efter de 5 dage går man tilbage til normal kost, men man starter langsomt.
- Dag 6: Let fordøjelig mad (f.eks. frugt, ris, suppe). Undgå tungt kød og sukkerchok med det samme.
Se også Ketogen Kost og LCHF
Vigtigt: Vær opmærksom på, at man ikke må være underernæret (BMI under 18.5) før start.
Vigtigt: Diæten bør koordineres med onkologen, da den kan påvirke blodsukkeret og medicinbehovet.
Fødevaregrupper i detaljer

Longos protokol er strengt plantebaseret i de 5 dage.
Longos tilgang
Valter Longo udtaler: “Faste handler ikke kun om kalorier, men om sammensætningen.” Hvis man spiser 800 kalorier ren sukker, opnår man ikke effekten. Det skal være fedt og komplekse fibre, der ikke trigger insulin.
- Tilladt: Nødder (macadamia, valnødder), oliven, grønne grøntsager, urtete, vand, citron.
- Forbudt: Kød, mælkeprodukter, frugt (pga. sukker), stivelse (kartofler/brød), kaffe (kan diskuteres, men ofte frarådet pga. binyrestress).
Relevans ved kræft
Longo-protokollen er relevant for patienter, der ønsker at bruge kosten aktivt til at forbedre deres standardbehandling.
Beskyttelse mod bivirkninger
Studier viser, at patienter på FMD ofte oplever mindre kvalme, træthed og færre skader på immunsystemet (neutropeni) under kemoterapi. [4]
Øget behandlingseffekt
Metoden henvender sig til dem, der vil optimere deres odds. I museforsøg har kombinationen af FMD og kemo vist sig at kunne helbrede kræftformer, som kemo alene ikke kunne røre.
Videnskabelig tyngde
I modsætning til mange andre kure, er denne protokol testet i randomiserede kliniske forsøg på hospitaler verden over (bl.a. Holland og USA).
Overvejelser og risici

Selvom det er mad, er det en kraftig intervention. Kroppen stresses fysiologisk.
Vægttab og muskeltab
Kræftpatienter kæmper ofte med vægttab. FMD medfører uundgåeligt vægttab. Det er kritisk at sikre, at man genvinder vægten i perioderne mellem cyklusserne (re-feed perioden).
Blodsukkerfald
Patienter på diabetesmedicin skal være ekstremt varsomme, da kombinationen med faste kan give livsfarligt lavt blodsukker. Drøft derfor dette med din behandler.
Ingen erstatning for behandling
Longo understreger altid: “Dette er integrativ medicin”. Det erstatter ikke kemo eller stråler, men får det til at virke bedre. Diæten alene kan sjældent fjerne kræft, men den kan bremse væksten.
Interaktion
Man bør ikke tage høje doser af antioxidanter (C-vitamin, E-vitamin) under FMD-dagene, da det kan modvirke den oxidative stress, som skal dræbe kræftcellerne.
Hvilken behandling tilbød Valter Longo

Da Longo er forsker, refererer vi her til de patientcases og studier, han har publiceret.
Casen (fra kliniske forsøg):
- I studier med brystkræftpatienter (DIRECT-studiet) blev deltagere inddelt i to grupper.
Konventionel behandling:
- Alle modtog standard kemoterapi.
Interventionen:
- Halvdelen fulgte FMD-protokollen i dagene omkring hver kemobehandling, mens den anden halvdel spiste normalt.
Resultatet:
- FMD-gruppen havde markant færre bivirkninger. Deres DNA i de hvide blodlegemer var mindre beskadiget.
- Senere analyser har indikeret, at patienter, der fulgte diæten strikst, havde en bedre tumor-respons (kræften skrumpede mere) og potentielt bedre overlevelse. [5]
Potent strategi ved resistent kræft

Protokollen adresserer problemet med, at kræftceller gemmer sig. Når man faster, falder niveauet af stoffet “Heme Oxygenase-1” i kræftcellerne. Dette gør, at kroppens egne T-celler (dræberceller) pludselig kan “se” kræften og angribe den.
FMD kan derfor potentielt gøre “kold” kræft (som immunsystemet ignorerer) til “varm” kræft, der kan angribes, hvilket gør den særligt interessant i kombination med moderne immunterapi. [6]
Vigtige advarsler

Faste er en kraftig metabolisk stress-test, og for svækkede patienter er der risici.
Diabetes og ketoacidose
Hvis du tager insulin eller metformin, må du aldrig faste uden lægelig overvågning.
Problemet:
- Medicinen sænker blodsukkeret, og fasten sænker det yderligere. Du risikerer insulinchok (hypoglykæmi).
- Hvis du har type 1 diabetes, kan manglen på insulin under faste føre til livsfarlig syreforgiftning (ketoacidose).
Galdeblære-anfald
Når man faster og derefter spiser fedtholdig mad (nødder/olie), skal galdeblæren arbejde hårdt.
Problemet:
- Hvis du har galdesten, kan fasten udløse et akut anfald. Har du fået fjernet galdeblæren, kan det høje fedtindhold i FMD give diarré – i nogle tilfælde i voldsom grad.
Kritisk vægttab (kakeksi)
Den største risiko ved faste under kræftbehandling er tab af muskelmasse.
Problemet:
- Hvis dit BMI er under 18,5, eller hvis du allerede har tabt dig meget uplanlagt, bør du ikke faste.
- Immunforsvaret kræver proteiner for at fungere. Faste kan i denne situation svække dig mere, end den gavner.
Se også Undervægt ved kræft
Se også Bevar muskelmasse
Sikkerhed
Rådfør dig altid med din behandler før du begynder på en protokol.
Vigtigt ved kemoterapi og lave blodplader

Mange af de stoffer, der bekæmper kræft effektivt (især i denne protokol), virker også blodfortyndende. Hvis kemoterapi har sænket dine blodplader (trombocytter) til et kritisk niveau, skal du være ekstra varsom.
Hvad du bør pausere ved lave blodplader
Hvis dine tal er i bund, bør følgende stoffer sættes på pause for at undgå blødningsrisiko, indtil marven er restitueret:
- Fedtsyrer: Omega-3/ fiskeolie/ hørfrøolie (Kraftigt blodfortyndende), Levertran, Hørfrøolie (Budwig) og Krillolie.
- Urte-ekstrakter (højdosis): Curcumin/ gurkemeje, Ingefær, hvidløg (i store doser/ kapsler), ginkgo biloba og Ginseng. (Hæmmer blodpladernes evne til at klumpe sammen).
- Enzymer: Proteolytiske enzymer som Bromelain, Papain og Serrapeptase (da disse nedbryder fibrin, som hjælper blodet med at størkne).
- Specifikke Antioxidanter: E-Vitamin, Resveratrol, Quercetin og stærk Grøn Te-ekstrakt (EGCG).
- Off-label medicin: Aspirin, Magnyl eller Hjertemagnyl (skal stoppes øjeblikkeligt ved lave plader, medmindre andet er aftalt med lægen).
Støtte til knoglemarven
Der findes strategier, der specifikt støtter dannelsen af blodplader uden at modvirke behandlingen:
- Melatonin: Studier viser, at melatonin kan beskytte knoglemarven mod kemo-skader (tages ved sengetid).
- Papaya-bladekstrakt: Kendt for potentielt at kunne øge antallet af blodplader.
- Klorofyl: Grønne juicer (spinat/grønkål) leverer K-vitamin, som understøtter blodets koagulering.
- Hajleverolie (alkylglyceroler): Kan stimulere dannelsen af hvide blodlegemer og plader (bør dog ikke tages på selve kemo-dagene).
NB: Du bør altid vende dit indtag af kosttilskud med din onkolog.
Bugspytkirtelkræft (KRAS-mutationer)

Valter Longos forskning er særligt interessant her, da bugspytkirtelkræft ofte drives af en mutation i KRAS-genet, som gør cellerne meget modstandsdygtige.
Longos studier tyder på, at når man kombinerer faste-lignende diæt (FMD) med høje doser C-vitamin (IV), kan man “snyde” disse muterede celler og gøre dem sårbare over for celledød.
Desuden har hans forskning vist, at faste kan stimulere regenerering af raske celler i netop bugspytkirtlen.
Konklusion

Valter Longos protokol repræsenterer et paradigmeskift, hvor mad betragtes som medicinsk teknologi. Den udfordrer tanken om, at kræftpatienter altid skal “spise hvad de har lyst til” for at holde vægten.
For onkologen er det et værktøj til at mindske toksicitet. For patienten er det en måde at tage kontrol og aktivt deltage i kampen mod kræftcellerne.
Protokollen tilbyder en konkret handling, nemlig at sulte kræften, mens man styrker kræftens raske celler. Det er videnskab omsat til måltider.
Se også Immunterapi
Eksempel på en dag på protokollen (dag 2-5)

Dagen er præget af små mængder mad og meget væske.
Morgenmad: Urtete (uden sukker) og en nøddebar (højt fedtindhold, lav sukker) specifikt sammensat til formålet.
Frokost: En lille portion grøntsagssuppe (f.eks. tomat eller svampe) tilsat ekstra olivenolie for mæthed, samt et tilskud af algeolie (Omega-3).
Eftermiddag: Urtete og evt. et par oliven.
Aften: Grøntsagssuppe og en lille kiks/ cracker med lavt kulhydratindhold.
Løbende: Masser af vand. Ingen fysisk hård træning, kun lette gåture.
Se også Faste
Links
[1] Fasting and cancer: molecular mechanisms and clinical application (PubMed, Nature Reviews Cancer, 2018)
- Indhold: En omfattende videnskabelig gennemgang af Valter Longo og kolleger, der beskriver de molekylære mekanismer (IGF-1, mTOR), hvorved faste og FMD kan øge effekten af kræftbehandling og beskytte normale celler.
[2] Starvation-dependent differential stress resistance protects normal but not cancer cells against high-dose chemotherapy (PubMed, PNAS, 2008)
- Indhold: Det banebrydende studie, der introducerede begrebet “Differential Stress Resistance”. Studiet viste, at kortvarig sult beskyttede mus mod dødelige doser af kemoterapi, mens kræftcellerne ikke blev beskyttet.
[3] Fasting-mimicking diet reduces HO-1 to promote T cell-mediated tumor cytotoxicity (PubMed, Cancer Cell, 2016)
- Indhold: Et studie der viser, hvordan FMD ikke kun virker metabolisk, men også aktiverer immunsystemet (T-celler) til at angribe brystkræft og modermærkekræft, især i kombination med kemoterapi.
[4] Fasting mimicking diet as an adjunct to neoadjuvant chemotherapy for breast cancer in the DIRECT trial (PubMed, Nature Communications, 2020) Indhold: Resultaterne fra et randomiseret klinisk forsøg med brystkræftpatienter. Studiet konkluderer, at FMD er sikkert at gennemføre, reducerer kemo-relateret DNA-skade i immunceller og viser tegn på øget tumorrespons.
[5] Longevity Diet for Adults (Hjemmeside, Valter Longo, 2019)
- Indhold: Siden hvor Valter Longo præsenterer protokollen for et bredere publikum. Her beskrives både hverdagsdiæten for et langt liv og den specifikke 5-dages FMD-kur til sygdomsbehandling.
[6] Safety and Feasibility of Fasting-Mimicking Diet and Effects on Nutritional Status and Circulating Metabolic and Inflammatory Factors in Cancer Patients Undergoing Active Treatment (European Journal of Clinical Nutrition, 2021) Indhold: En undersøgelse der evaluerer sikkerheden ved FMD hos patienter med forskellige kræfttyper. Den bekræfter, at diæten generelt tolereres godt og ikke medfører alvorlig underernæring, når den udføres under opsyn.
Siden oprettet:
d. 06.12.25
❤
Hvad du læser på Jeg har Kræft er ikke en anbefaling. Søg kompetent vejledning.

